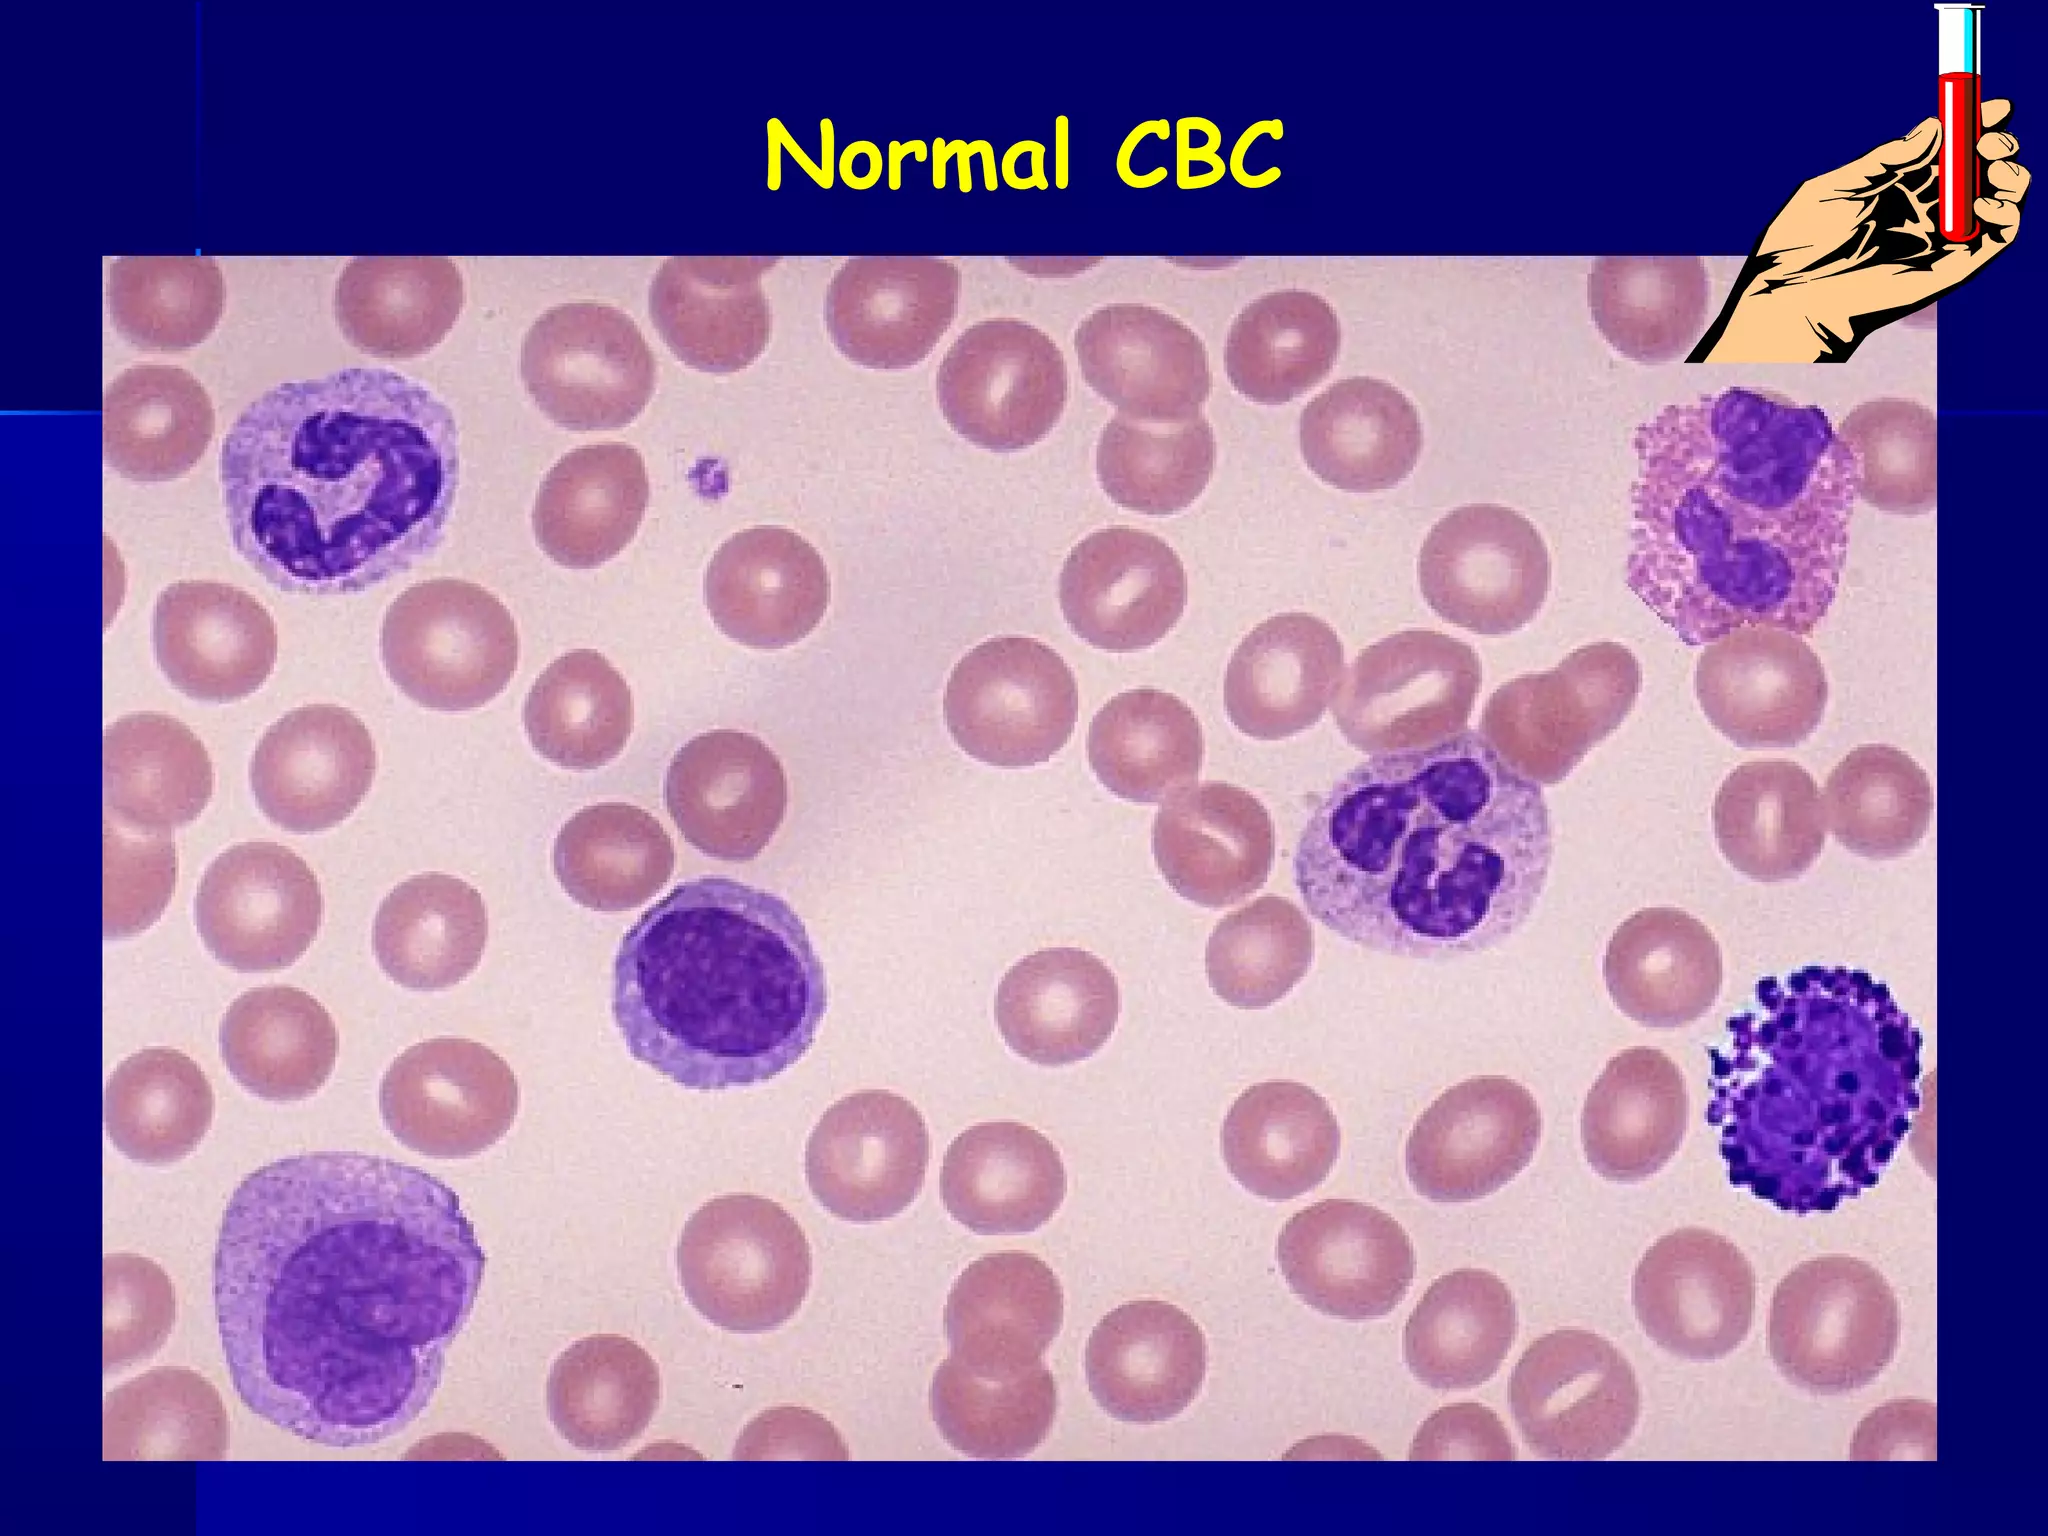
Normal CBC

Iron deficiency anemia is the most common nutritional deficiency in children worldwide. It occurs most frequently in infants aged 6-24 months, especially those who are artificially fed or from low socioeconomic backgrounds. Iron deficiency anemia develops in stages from iron depletion to iron deficiency to anemia, characterized by low iron stores, serum iron, and high total iron binding capacity. Clinically, it presents with pallor, fatigue, and impact on development in children. Treatment involves oral or parenteral iron replacement therapy, addressing the underlying cause, and ensuring an adequate iron intake.